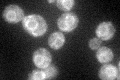
YKL122C
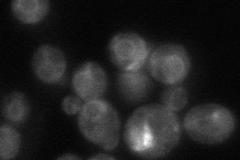
YKL122C
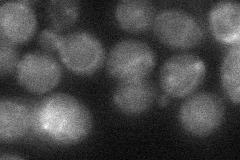
YKL122C
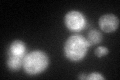
YKL122C
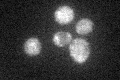
YKL122C

View description
Subunit of the signal recognition particle (SRP), which functions in protein targeting to the endoplasmic reticulum membrane; not found in mammalian SRP; forms a pre-SRP structure in the nucleolus that is translocated to the cytoplasm
Localization:
Intensity:
Fold change:
Significance:
-
C’ GFP library in SD
ER50.98 -
N' NOP1pr-GFP in SD

nucleolus125.148 -
N' TEF2pr-mCherry in SD

nucleus,nucleolus123.149 -
N' NATIVEpr-GFP in SD
ER62.0085 -
N' TEF2pr-VC and Cyto-VN in SD
cytosol32.9516 -
C’ GFP library in SD+DTT
ER51.961.01No -
C’ GFP library in SD+H2O2

ER50.620.99No -
C’ GFP library in Starvation Media
ER38.040.74No -
C’ GFP library on the background of Pup2-DaMP

ER -
C’ GFP library on the background of CCT mutant

ER49.97260.980057No
